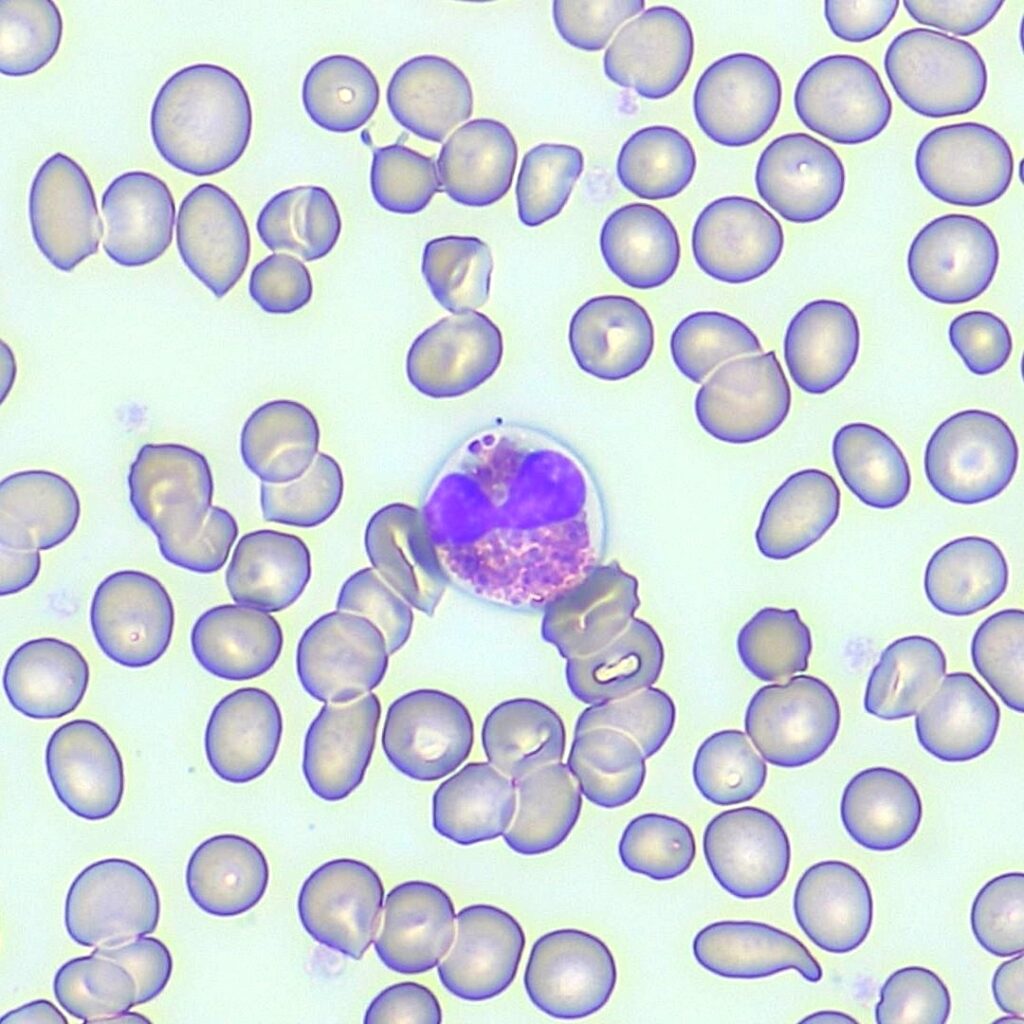
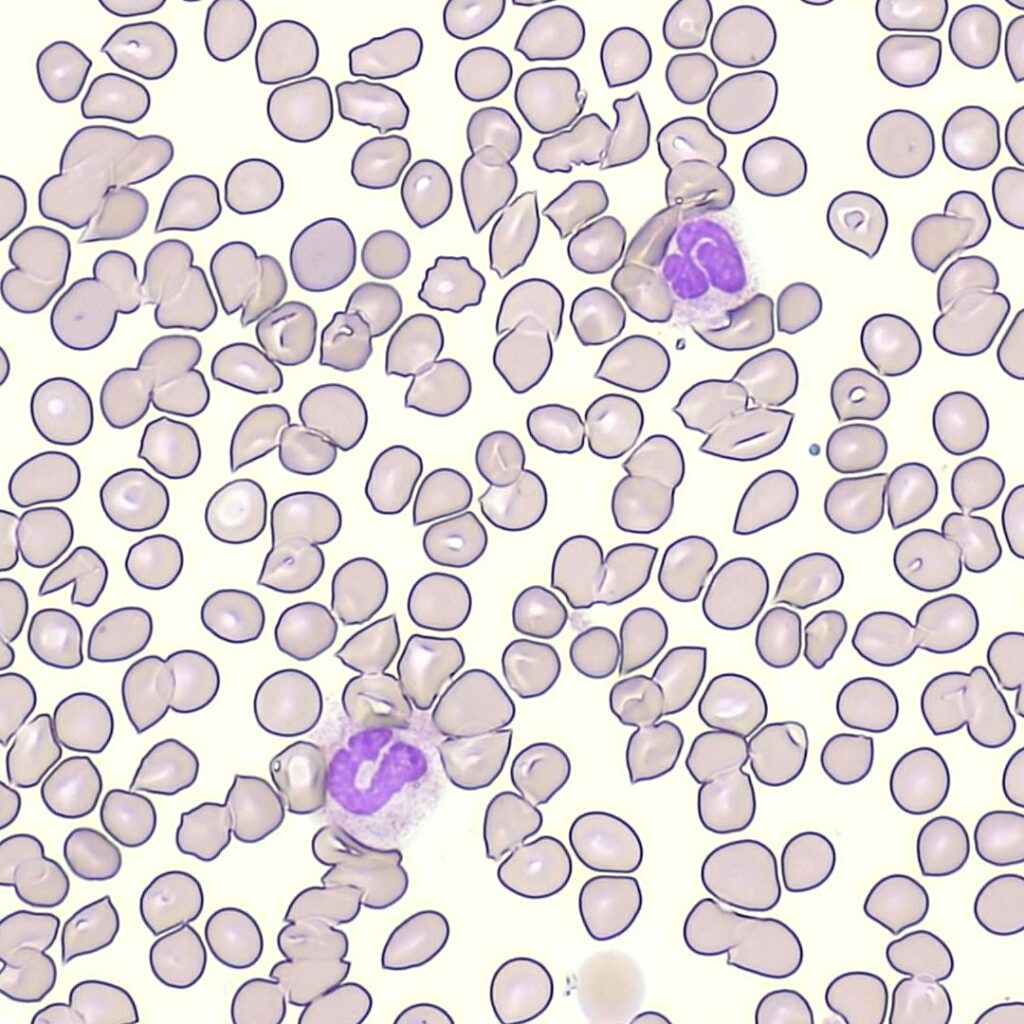

臨床検査科について
臨床検査科は検体検査(血液・尿などの検査と輸血検査)、生理機能検査(心電図、超音波検査など人体の検査)、病理検査(手術や内視鏡検査から採取された組織検査、尿、穿刺液などの検体による細胞診検査)を行う3部門からなっています。また、当院の検体検査部門では、2024年8月に国際規格ISO15189を取得しており。世界的な品質基準に準拠し、検査結果を提供しています。

スタッフ
臨床検査管理医1名を顧問に、臨床検査技師32名、看護師4名で当院検査室と関連施設の健診センターの検査業務を行っています。
当院の検査について
1.検体検査部門(ISO15189認定)
免疫検査
(1)採血
血液を用いた検査は体のさまざまな状態や病気の手がかりとなり、診断や治療に役立ちます。当院では年間に約33000件を超える採血を、看護師・臨床検査技師が安全に行っており、必要最小限の量で実施しご負担を少なくするよう心がけています。
受付について
受付にて「採血の順番票」を発行してください。その情報をもとに、自動採血管システムから専用の採血管が準備されます。


本人確認について
採血前には、ご自身に生年月日とフルネームを名乗っていただきます。誤認防止のため、ご協力をお願いします。

※お願い※
以下に該当する方は、必ず事前にスタッフへお知らせください。
・アルコール消毒で赤くなったことがある方
・テープでかぶれる方
・採血をしてはいけない腕がある方
・採血中に気分が悪くなったことがある方
(2)一般検査について
尿・便潜血・脳や脊髄を包んでいる水(脳脊髄液)、胸やお腹にたまる水(腹水や胸水)などを調べる一般検査を行っています。
尿検査
尿検査は、体への負担が少ない検査です。尿を採っていただき、尿コップに入れて提出していただきます。提出は、トイレ内にあるガラスの引き戸の受け渡し口に置いてください。

尿中のpH、蛋白、糖、潜血などの測定のほか、顕微鏡下で尿中の細胞成分(血球、上皮細胞、円柱、結晶など)を調べることで、腎臓や膀胱の状態・変化を知ることができます。


便潜血
便に含まれる血液の成分であるヘモグロビンを調べることで、消化管からの出血がないかを確認することができます。
脳脊髄液の検査
髄液の性状や細胞数を計測することで、髄膜炎や脳炎、くも膜下出血などの病気を見つける手がかりになります。
体腔液の検査
採取された胸水や腹水の色調や性状を確認し、炎症や腫瘍の可能性を調べます。
(3)血液検査について
血液に含まれる成分である赤血球・白血球・血小板の数や、ヘモグロビン量の測定を行っています。さらに、顕微鏡を用いて血球の形の異常を調べる検査(血液像)も実施しています。
自動血球分析装置による検査
血球数の算定には、シスメックス社製の XN-2000 を使用しています。
・赤血球・白血球・血小板の数
・白血球の種類ごとの分布
・赤血球の大きさの情報
・網赤血球や未熟な白血球の検出
・胸水や腹水など体腔液の細胞数測定

血液像検査
自動分析で異常が見つかった場合や詳細な確認が必要なときには、顕微鏡を使って血液の塗抹標本を観察します。
血球の形態異常や幼若細胞の有無などを直接確認できる重要な検査です。

凝固検査
出血や血栓症の原因を調べるために、血液の固まりやすさを調べる検査も行っています。使用している装置は、積水メディカル社製の CP3000 です。
代表的な検査項目
プロトロンビン時間(PT)
活性化部分トロンボプラスチン時間(APTT)
フィブリノーゲン量
Dダイマー

(4)生化学・免疫検査について
当院の検査室では、シーメンス社製 Atellica CH/IM システム を用いて、生化学検査および免疫検査を行っています。

自動分析装置 Atellica CH/IMにより、生化学検査業務の自動化が実現し、人が手作業で検体を扱う場面を減らすことで、より安心・安全な検査体制が構築できています。
生化学検査
総タンパク、アルブミンなどのタンパク質、タンパク質代謝の副産物であるアンモニア、尿素窒素、クレアチニンなどの窒素化合物、コレステロールや中性脂肪などの脂質、ビリルビンなどの色素、ナトリウム・カリウムなどの電解質、鉄などの金属、AST・ALTなどの酵素の測定を行っています。
免疫検査
腫瘍マーカー、肝炎ウイルス関連検査、甲状腺ホルモン、心疾患関連マーカー、炎症マーカーなどを測定しています。


(5)輸血検査について
安全な輸血を実施するためには、輸血副作用の予防とともに輸血過誤の防止が欠かせません。当院では安全に輸血を受けていただくために、以下の検査・管理を行っています。
・血液型検査(ABO式・Rh式)
・不規則抗体検査(まれに存在する抗体を見つける検査)
・交差適合試験(クロスマッチ、患者さんの血液と輸血用血液の適合性を確認する検査)
これらの検査は、ORTHO VISION全自動輸血検査装置を用いて実施しており、輸血前の安全確認を行っています。

その他には輸血用血液製剤(赤血球製剤・新鮮凍結血漿・濃厚血小板)やアルブミン製剤の発注・保管・各部署への払い出し、輸血歴の管理も行っています。
また、自己血輸血の際には採血補助と保管管理を担当しています。
輸血の適正使用を推進するため、輸血療法委員会を開催し、使用状況や廃棄率の報告・改善、輸血の際に生じた副作用の報告共有に取り組んでいます。
(6)微生物検査について
微生物検査室では、血液・尿・喀痰・膿・分泌物・便などから、感染症の原因となる細菌や真菌を培養し、どの抗生物質が効くか(薬剤感受性試験)を調べています。

また、顕微鏡を用いた形態観察も行っています。


時間外でも迅速な診断を必要とする感染症に対しては、インフルエンザの抗原抗体反応、新型コロナウイルスの遺伝子検査(PCR検査)も実施しています。

2.生理機能検査部門
(1)心電図検査
安静心電図
胸に電極を貼り付けて、心臓が拍動する際に発生する微弱な電気信号を波形として記録し、心臓の状態を調べる検査です。
心筋梗塞や狭心症、不整脈などの診断に用いられます。検査時間は 約3〜5分 です。

負荷心電図(マスター2階段負荷試験・トレッドミル負荷試験)
階段の昇降や電動で動くベルトの上を歩く(又は走る)事によって心臓に運動負荷をかけ、負荷前後の心電図変化を調べる検査です。運動時にのみ現れる潜在的な虚血性心疾患の発見に役立ちます。検査時間は 約20〜30分 です。


24時間ホルター心電図
24時間にわたり胸に電極を貼り付けて、心電図を連続記録する検査です。
日常生活中の不整脈や心筋虚血の有無を詳しく調べることができます。

(2)血圧脈波検査(CAVI/ABI/TBI)
腕・足首・足趾に血圧計を装着し、血圧や脈の伝わり方を測定して血管の硬さ(動脈硬化の程度)や血管の狭窄や閉塞がないかを調べる検査です。
検査時間は 約15〜20分 です。
動脈硬化は心筋梗塞や脳梗塞の原因となることがあり、早期発見・生活習慣病予防に役立ちます。
当検査室では、最新の測定機器を2台導入しています。

(3)超音波検査(心臓・腹部・血管・乳腺・甲状腺など)
超音波(エコー)とは、耳に聞こえないほど高い周波数の音波を体に当て、その反射を画像化して体の内部を観察する検査です。人体に害がなく、痛みや苦痛を伴わないのが特徴です。
心臓、肝臓・胆嚢・腎臓・膵臓などの腹部臓器、乳腺・甲状腺などの体表臓器、頸動脈・下肢動静脈・透析用シャント血管評価など、幅広い領域の診断に役立ちます。
又、肝硬変の診断に有用な肝硬度(肝臓の硬さ)も計測できる最新の超音波装置を導入しています。
検査時間は 約15〜60分 です。




(4)肺機能検査
息を吸ったり吐いたりする量や勢いを測定して、肺の状態を調べる検査です。
肺活量と努力性肺活量を測定し、喘息・慢性閉塞性肺疾患(COPD)などの呼吸器疾患の診断や手術前の呼吸機能評価として用いられます。
検査は口にマウスピースをくわえて息を大きく吸ったり、勢いをつけて吐いたりしてもらって行います。
検査時間は 約10〜15分 です。

(5)呼気NO濃度測定検査
呼気中の一酸化窒素(NO)濃度を測定し、気道の炎症の有無を調べる検査です。
NOは喘息でみられる「好酸球性気道炎症」があると増加するため、喘息の診断や治療効果の判定に役立ちます。
検査は口にマウスピースをくわえて息を一定の速度で吹くだけという簡単な検査です。
検査時間は約10分です。

(6)聴力検査(純音聴力検査・ティンパノメトリー)
ヘッドフォンを装着し、左右の耳に様々な高さや大きさの音を聞いてもらい、どの程度の音が聞こえるかを調べる検査です。難聴の程度や種類が診断できます。防音室内で行うため、静かな環境で正確な聴力が検査できます。
検査時間は 約15〜20分 です。


ティンパノメトリー(鼓膜・中耳機能検査)は、耳の中にやわらかいチップを当てて、鼓膜や中耳の動きを調べる検査です。痛みはなく短時間で終了します。中耳炎や耳のつまり、聞こえにくさの原因を調べる際に役立ちます。
(7)神経伝導速度検査
手足の神経に電気刺激を与え、その反応波を測定して末梢神経の損傷や障害の有無を調べる検査です。
手足のしびれ・こわばりなどの原因が、どの神経の障害によるものかを調べることができます。検査中はビリッとした電気刺激や痛みを感じることもあります。
心臓にペースメーカーを装着されている方は、安全のため検査できません。
検査時間は 約60分 です。
(8)睡眠時無呼吸検査・簡易睡眠時無呼吸検査
いびきが大きい、夜間に呼吸が止まる、日中に強い眠気がある、などの症状がある方に対して、睡眠中の呼吸の状態を調べる検査です。
また、終夜睡眠ポリグラフ検査:PSGでは、精密検査のため一晩お泊まりいただきます。専門の検査技師が様々なセンサーを装着し、脳波・呼吸・心電図・酸素濃度・筋肉の動きなどを同時に測定します。

詳しくは、睡眠時無呼吸外来の案内をご参照ください。
3.病理検査部門(病理診断科参照)
手術や検査で採取された組織や細胞を使って、病理医が正確な診断ができるように標本を作製しています。また、がんなどの病気を詳しく調べるために染色や検査も行っています。
チーム医療への取り組み
臨床検査科では、安心で質の高い医療を提供するために、医師・看護師・薬剤師など多職種と連携し、チーム医療や委員会の活動に積極的に取り組んでいます。
臨床検査技師は、検査データを通じて診断や治療方針の決定を支援し、医療の質向上に貢献しています。
主なチーム医療活動
ICT(感染制御チーム)
感染症の発生状況を微生物検査で検査し、院内感染の予防に協力
耐性菌の通報やアンチバイオグラム作成
褥瘡(じょくそう)対策チーム
傷の治りに関係する検査データを提供し、治療への支援
NST(栄養サポートチーム)
生化学検査などのデータを提供し、食事や栄養管理を支援
NST委員会への参加
糖尿病療養指導チーム
血糖やHbA1cなどの検査結果の提供
自己血糖測定機のデータ管理
糖尿病患者会「かがやき会」への参加
医療従事者向け情報
臨床検査科の医療従事者向け情報はこちらから
(資格者一覧・認定施設・外部精度管理調査など)
認定技師・資格者数
| 認定機関 | 取得資格 | 人数 |
| 日本臨床検査同学院 | 緊急臨床検査士 | 6 |
| 二級臨床検査士(病理) | 4 | |
| 二級臨床検査士(微生物) | 2 | |
| 二級臨床検査士(循環生理学) | 1 | |
| 日本輸血細胞治療学会 | 認定輸血検査技師 | 1 |
| 日本臨床細胞学会 | 細胞検査士 | 5 |
| International Academy of Cytology(IAC) | 国際細胞検査士 | 1 |
| 日本超音波医学会 | 超音波検査士(消化器) | 5 |
| 超音波検査士(循環器) | 4 | |
| 超音波検査士(血管) | 4 | |
| 超音波検査士(体表) | 3 | |
| 超音波検査士(泌尿器) | 2 | |
| 超音波検査士(健診) | 1 | |
| 4学会構成血管診療技師認定機構 | 血管診療技師 | 2 |
| 日本睡眠総合健診協会 | CPAP療法士上級者 | 2 |
| 日本糖尿病療養指導士認定機構 | 日本糖尿病療養指導士 | 2 |
| 日本臨床栄養代謝学会 | 栄養サポートチーム専門臨床検査技師 | 1 |
| 医療情報学会 | 認定医療情報技師 | 2 |
| 健康食品管理士認定協会 | 健康食品管理士 | 1 |
| 日本臨床衛生検査技師会 | 認定臨床化学・免疫化学精度保証管理検査技師 | 2 |
| 認定病理検査技師 | 1 | |
| 認定一般検査技師 | 1 | |
| その他 | 一般毒物劇物取扱者 | 2 |
| 特定化学物質等作業主任者 | 2 | |
| 有機溶剤作業主任者 | 2 | |
| 特別管理産業廃棄物管理責任者 | 1 |
認定施設
- ISO15189認定施設(認定番号 RML03280)
- 品質保証施設認証制度認定施設(第24-0190号)
- 日本輸血・細胞治療学会 認定輸血検査技師制度指定施設(No.189)
- 日本臨床細胞学会 認定施設 (No.803)
外部精度管理調査参加
- 日本医師会 臨床検査精度管理調査
- 日本臨床検査技師会 臨床検査精度管理調査
- 大阪府医師会 臨床検査精度管理調査
- 大阪府臨床検査技師会 臨床検査データ標準化サーベイ
- 日本臨床細胞学会 コントロールサーベイ
| 外部精度管理調査団体名 | 評価 |
| 日本医師会 | 96.6点 |
| 日本臨床衛生検査技師会 | 評価A+B 99.2%、評価C 0.4%、評価D 0.4% |
臨床検査を終了した残余検体の使用についてのお願い
社会医療法人景岳会南大阪病院 診療支援部 臨床検査科では、より良い臨床検査の提供を目指して、検査の精度管理の向上、医療従事者の教育、新規検査機器の導入等の取り組みを行っています。「臨床検査を終了した既存資料(残余検体)の研究、業務、教育のための使用について –日本臨床検査医学会の見解-」を遵守し、以下のように残余検体の一部を 再利用いたします。上記趣旨をご理解いただき、ご協力を賜りますようお願いいたします。
1.対象残余検体について
当院で臨床検査が行われた後の残余検体を対象とします。(当院では通常、検査終了後約1週間保存されたのち適切な方法で廃棄されます。
2.使用目的について
以下の目的で残余検体を使用させていただきます。
- 検査の精度管理、新規機器・検査の導入等の日常業務における品質の向上
- 病院実習等の医学系教育
3.個人情報について
対象の残余検体は、氏名・生年月日・住所・電話番号などの個人情報をすべて削除してから使用されますので、個人情報が漏れることはありません。また、患者様の生命・健康に直接影響を及ぼすこともなく、診療上の不利益を受けることもありません。
臨床検査を受けられる患者様におかれましては、残余検体の上記利用にご理解、ご協力いただきますようお願いいたします。なお、残余検体の利用に関してご質問のある場合は、診療支援部 臨床検査科までご連絡下さい。